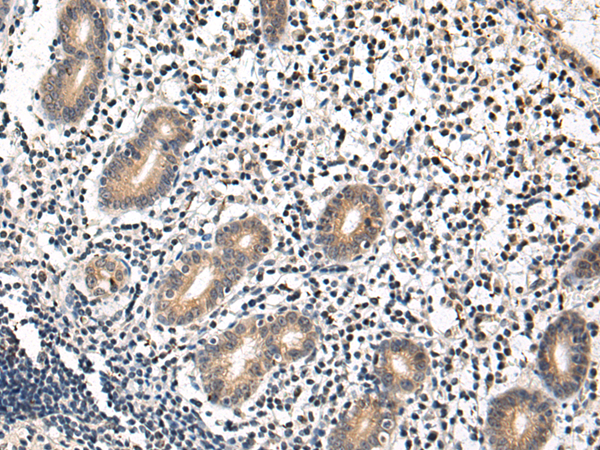
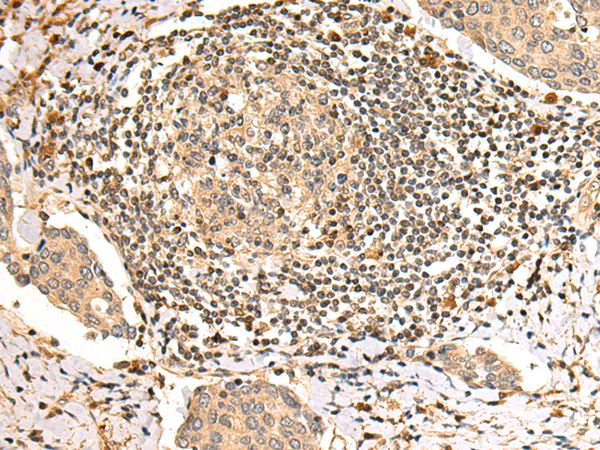
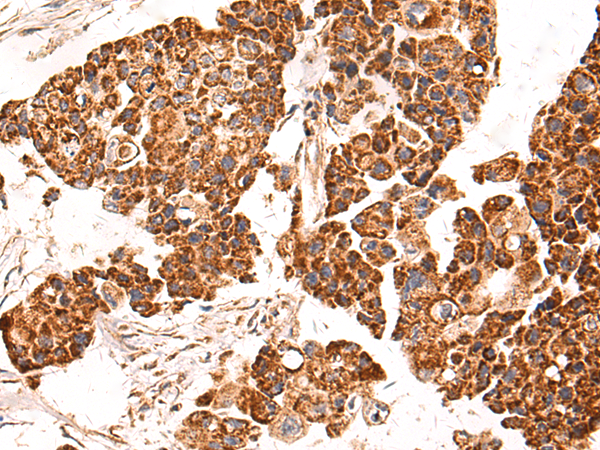
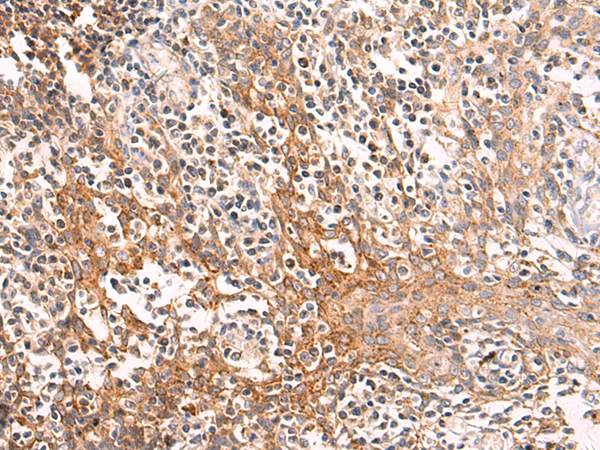
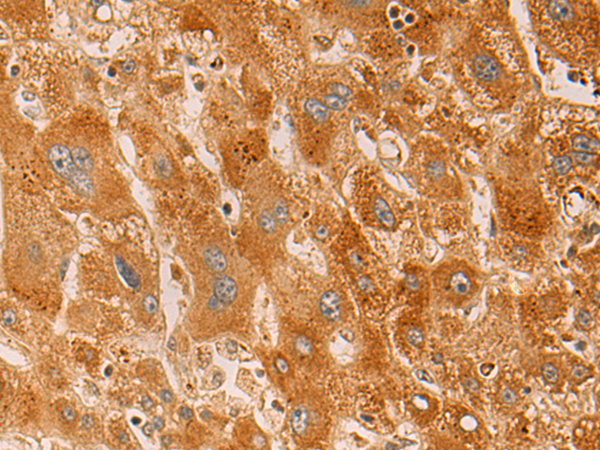

-
分类: 科研抗体货号: P10591别名: S10; DBA9应用: WB,IHC反应种属: Human, Mouse, Rat
-
分类: 科研抗体货号: P10570别名: LCB2; SPT2; HSN1C; LCB2A; NSAN1C; hLCB2a应用: WB,IHC反应种属: Human, Mouse, Rat
-
分类: 科研抗体货号: P10589别名: CAN19; S100L应用: WB,IHC反应种属: Human
-
分类: 科研抗体货号: P10569别名: CDG1T; GSD14应用: WB,IHC反应种属: Human, Mouse, Rat
-
分类: 科研抗体货号: P10588别名: kr-ZNF3应用: WB,IHC反应种属: Human, Rat
-
分类: 科研抗体货号: P10568别名: BAT5; NG26; PP199; hBAT5; D6S82E应用: WB反应种属: Human, Mouse, Rat
-
分类: 科研抗体货号: P10587别名: SLC55A1应用: WB,IHC反应种属: Human, Mouse, Rat
-
分类: 科研抗体货号: P10567别名: TUG; ASPL; ASPS; RCC17; UBXD9; UBXN9; ASPCR1应用: WB,IHC反应种属: Human, Mouse
-
分类: 科研抗体货号: P10585别名: GRP3应用: WB,IHC反应种属: Human
-
分类: 科研抗体货号: P10566别名: RAP80; X2HRIP110应用: WB,IHC反应种属: Human

鄂公网安备42018502007531号
鄂公网安备42018502007531号

